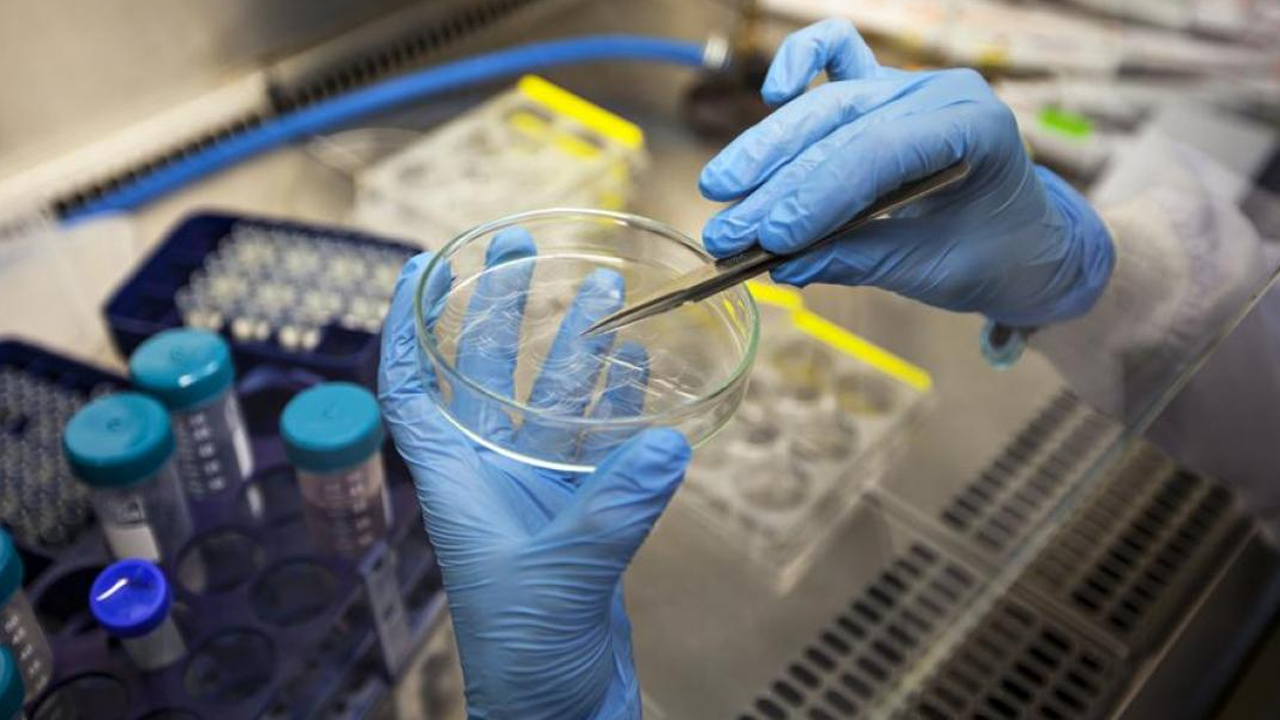
Yeni Salgın Kapıda! Türkiye’de de Görüldü, Belirtileri Grip ile Aynı… Test Yapılmadan Fark Edilmiyor - Resim : 3

Yeni Salgın Kapıda! Türkiye’de de Görüldü, Belirtileri Grip ile Aynı… Test Yapılmadan Fark Edilmiyor
Çok sayıda insanın hayatını kaybettiği, dünyanın yarısını esir alan Covid-19 salgınının yeni varyantı "Frankenstein varyantı” endişe yarattı. Özellikle ileri yaş grupları ve kronik hastalığı olanların risk altında olduğunu belirten uzmanlar, belirtilerin grip ile karıştırılabileceğini söyledi.

Covid-19'un dünya genelinde gündeme oturan yeni türü "Frankenstein varyantı", kış mevsiminin başlaması ile yeniden alarm verdi.
Birden fazla alt varyantın birleşmesiyle oluşan, bilim insanları tarafından "hibrit bir Covid-19 türü" olarak tanımlanan Frankenstein varyantı, bağışıklık sistemini daha kolay atlatabiliyor.

Farklı mutasyonları bünyesinde barındırdığı için kamuoyunda “Frankenstein” adıyla anılan bu varyant, hali hazırda bazı ülkelerde vaka artışlarına sebep olmuş durumda.
BELİRTİLER GRİP İLE KARIŞTIRILABİLİR
Enfeksiyon Hastalıkları ve Klinik Mikrobiyoloji Uzmanı Dr. Deniz Dazkır, varyanta dair dikkat çeken semptomları paylaştı.

TEST YAPILMADAN FARK EDİLMİYOR
Dr. Dazkır’a göre, Frankenstein varyantına yakalanan kişilerde sıklıkla boğaz ağrısı, burun akıntısı, baş ağrısı ve halsizlik görülüyor. Tat ve koku kaybının ise önceki varyantlara göre daha az rastlandığına dikkat çeken uzman, bazı hastalarda sindirim sistemi problemlerinin öne çıktığını ifade etti.
Covid-19’un bu varyantının, klasik grip ya da basit bir soğuk algınlığıyla karıştırılabildiğini vurgulayan Dr. Dazkır, “Test yapılmadığında hastalık fark edilmeyebiliyor. Bu da bulaş zincirinin uzamasına neden oluyor” dedi.
RİSKLİ GRUPLAR DİKKAT!
Frankenstein varyantı, özellikle bağışıklığı düşük bireyler, ileri yaş grupları ve kronik hastalığı olanlar için daha büyük bir tehdit oluşturuyor. Bu gruplarda hastalığın daha ağır seyredebileceğini belirten Dr. Dazkır, maske kullanımı ve hijyenin ihmal edilmemesi gerektiğinin altını çizdi.
AŞILAR GÜNCEL OLANLAR DAHA ETKİLİ
Varyantın, mevcut aşıların koruyuculuğunu kısmen azaltabildiği bilinse de, aşıların ağır hastalık ve ölüm riskini belirgin şekilde düşürdüğü vurgulandı. Güncellenmiş aşıların bu hibrit varyanta karşı daha etkili olduğunu söyleyen Dazkır, “Aşıların tamamen etkisiz olduğu yönündeki inanış doğru değil. Aşılama halen en güçlü silahlarımızdan biri” dedi.

KAPALI ALANLARDA MASKE ÖNERİSİ
Dr. Dazkır, sonbahar ve kış aylarında özellikle toplu taşıma, alışveriş merkezleri gibi kalabalık kapalı alanlarda maske kullanımını önerdi. Aynı zamanda el hijyenine dikkat edilmesi ve hastalık belirtisi gösteren bireylerin kalabalıktan uzak durmasının bulaşı azaltmada önemli rol oynadığını söyledi.
TÜRKİYE’DE DE GÖRÜLDÜ
Türkiye’de de Frankenstein varyantının görüldüğünü belirten uzman, sağlık otoritelerinin süreci yakından izlediğini, vatandaşların ise bireysel korunma önlemlerine mutlaka dikkat etmesi gerektiğini ifade etti.
Kaynak: AA









